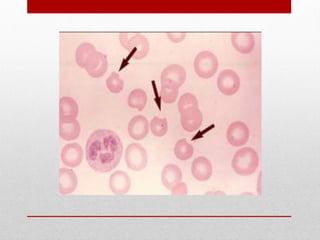
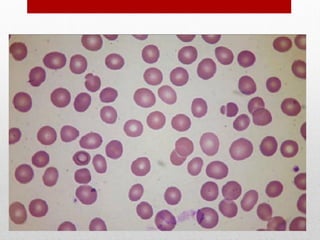

The document provides an in-depth overview of hemolytic anemia, explaining its types, underlying mechanisms, and the physiology of red blood cell breakdown. It discusses inherited and acquired forms of anemia, detailing conditions like G6PD deficiency, pyruvate kinase deficiency, hereditary spherocytosis, and autoimmune hemolytic anemia. Additionally, it covers diagnostic features, management strategies, and the biochemical pathways involved in red cell destruction and compensation by the bone marrow.